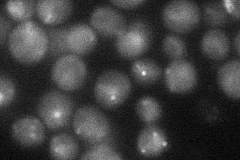

View description
Mitochondrial component of the ERMES complex that links the ER to mitochondria and may promote inter-organellar calcium and phospholipid exchange as well as coordinating mitochondrial DNA replication and growth
Localization:
Intensity:
Fold change:
Significance:
-
C’ GFP library in SD

punctate23.66 -
N' NOP1pr-GFP in SD

punctate46.5748 -
N' TEF2pr-mCherry in SD
punctate24.6995 -
N' NATIVEpr-GFP in SD

punctate,mitochondria19.7144 -
N' TEF2pr-VC and Cyto-VN in SD

below threshold25.197 -
C’ GFP library in SD+DTT

punctate24.581.03No -
C’ GFP library in SD+H2O2

punctate27.71.17No -
C’ GFP library in Starvation Media

punctate18.150.76Yes -
C’ GFP library on the background of Pup2-DaMP

punctate -
C’ GFP library on the background of CCT mutant

punctate24.91921.05314No
